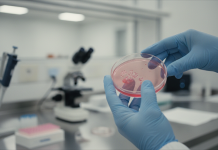
AI malattie rare: come l’intelligenza artificiale rivoluziona la cura AI malattie rare: ricercatori utilizzano intelligenza artificiale per la scoperta di nuovi farmaci

La nuova ossessione del wellness si chiama NAD+

Grazie per avere letto questo articolo, non dimenticare di iscriverti al nostro feed!
È probabile che anche tu abbia sentito parlare di NAD+. I Bieber lo assumono per via endovenosa, Joe Rogan ne ha parlato nei suoi podcast, e Gwyneth Paltrow – ovviamente – vende la sua crema arricchita con NAD+. Questo coenzima è diventato il nuovo oggetto del desiderio per chi cerca di ottimizzare salute e longevità.
Ma cosa c’è dietro questa tendenza? NAD+ (nicotinammide adenina dinucleotide) è una molecola che il nostro corpo produce naturalmente e che svolge un ruolo cruciale nella produzione di energia cellulare e nella funzione immunitaria. L’interesse crescente per la supplementazione di NAD+ riflette un cambiamento più ampio nel modo in cui pensiamo all’invecchiamento: non più solo reazione ai sintomi, ma prevenzione attiva.
Cos’è il NAD+ e perché è importante
Il NAD+ è un coenzima presente in tutte le cellule viventi. Il suo ruolo principale è convertire i nutrienti in ATP (adenosina trifosfato), la molecola che le cellule utilizzano come fonte di energia. Pensate al NAD+ come a un corriere di energia: trasporta elettroni ai mitocondri, dove viene prodotto l’ATP.
Ma non si ferma qui. Il NAD+ è coinvolto nella funzione immunitaria, nella segnalazione cellulare e nell’attivazione delle sirtuine, proteine che regolano la riparazione del DNA, l’infiammazione e le risposte allo stress ossidativo. “Se le nostre cellule non hanno energia, i neuroni non possono inviare segnali ad altri neuroni”, spiega Paul Barrett del National Institute on Aging. “Perdere la capacità di produrre energia ha un impatto profondo su molte funzioni biologiche.”
Perché i livelli di NAD+ diminuiscono
Se il corpo produce già NAD+, perché dovremmo integrarlo? La risposta è semplice: il NAD+ viene costantemente consumato e, con il tempo, diventa più difficile sostituirlo. Ogni volta che le cellule producono energia, il NAD+ viene utilizzato. Sebbene il corpo abbia meccanismi di riciclo, parte di questa riserva va persa.
Inoltre, i livelli di NAD+ diminuiscono naturalmente con l’età. Secondo la dottoressa Amanda Khan, specialista in medicina della longevità, le persone potrebbero aver perso metà dei loro livelli di NAD+ entro i 40 anni, anche se genetica e fattori ambientali giocano un ruolo importante. Anche lo stile di vita – alcol, stress, infezioni – accelera questa deplezione.
I potenziali benefici (e cosa dice la ricerca)
La maggior parte degli studi non si concentra sul NAD+ diretto, ma sui suoi precursori: composti che il corpo può convertire in NAD+ una volta all’interno delle cellule. I più comuni sono NR (nicotinammide riboside), NMN (nicotinammide mononucleotide), NA (acido nicotinico), NAM (nicotinammide) e triptofano.
Secondo Khan, alcuni pazienti riportano miglioramenti in termini di energia, chiarezza mentale, emicranie e disturbi del ritmo circadiano dopo l’uso di terapie correlate al NAD+. “Ho molti appassionati di fitness come pazienti, che recuperano meglio dopo un infortunio o un allenamento intenso”, aggiunge.
La ricerca preliminare sta anche esplorando il ruolo del NAD+ nelle malattie neurodegenerative, nei percorsi del dolore infiammatorio e nella dipendenza. Tuttavia, ciò che rimane poco chiaro è se iniziare l’integrazione possa prevenire le malattie o alterare significativamente la traiettoria dell’invecchiamento.
Sicurezza ed effetti collaterali
Tra i booster di NAD+, gli integratori di NR hanno i dati di sicurezza più solidi. Sono stati studiati in dosi che vanno da 1.000 a 3.000 milligrammi al giorno in adulti sani, con effetti collaterali minimi o nulli.
La niacina, un altro precursore del NAD+, è efficace ma meno popolare perché dosi elevate possono causare arrossamento del viso e aumento della frequenza cardiaca. Studi su animali hanno sollevato preoccupazioni sul fatto che dosi estremamente elevate di precursori del NAD+ potrebbero promuovere la crescita tumorale, il che ha portato i medici a essere cauti nei pazienti con cancro attivo.
È importante sottolineare che nessuno studio clinico sull’uomo ha mostrato un aumento del rischio derivante dai precursori orali del NAD+. La gravidanza rimane un’altra area grigia: la maggior parte dei medici raccomanda di evitare gli integratori di NAD+ durante la gravidanza a causa della mancanza di dati sulla sicurezza.
Precursori orali vs infusioni endovenose
Alcuni prodotti affermano di fornire NAD+ direttamente, ma dal punto di vista fisiologico è improbabile che funzioni se assunto per via orale. Il NAD+ ha una scarsa biodisponibilità e non attraversa facilmente il tratto gastrointestinale o le cellule. Ecco perché la maggior parte degli esperti di longevità raccomanda i precursori.
Le infusioni endovenose di NAD+ sono diventate molto popolari, ma le prove a sostegno della loro efficacia sono scarse. “Il corpo vede quel NAD+ nel sangue e pensa che qualcosa non va”, spiega Rachele Pojednic di Stanford. “È lì che il fegato e i reni iniziano a lavorare, e finisci per eliminarne la maggior parte con le urine.”
I pazienti riportano anche frequentemente effetti collaterali con le infusioni, tra cui nausea, oppressione toracica e diarrea improvvisa. In breve, per la maggior parte degli adulti sani, i precursori orali rimangono l’opzione più semplice e meglio studiata.
Cosa non sappiamo ancora
La domanda più grande senza risposta è la causalità: il declino del NAD+ guida l’invecchiamento, o è l’invecchiamento stesso ad accelerare la perdita di NAD+? La maggior parte degli studi si concentra su persone che hanno già una malattia. Se l’integrazione precoce nella vita possa prevenire in modo significativo il declino legato all’età o estendere la durata della salute in persone altrimenti sane rimane non dimostrato.
Per ora, il NAD+ occupa uno spazio familiare nel mondo del wellness: biologicamente plausibile, generalmente sicuro se usato in modo appropriato e culturalmente onnipresente, ma ancora in attesa di risposte definitive.